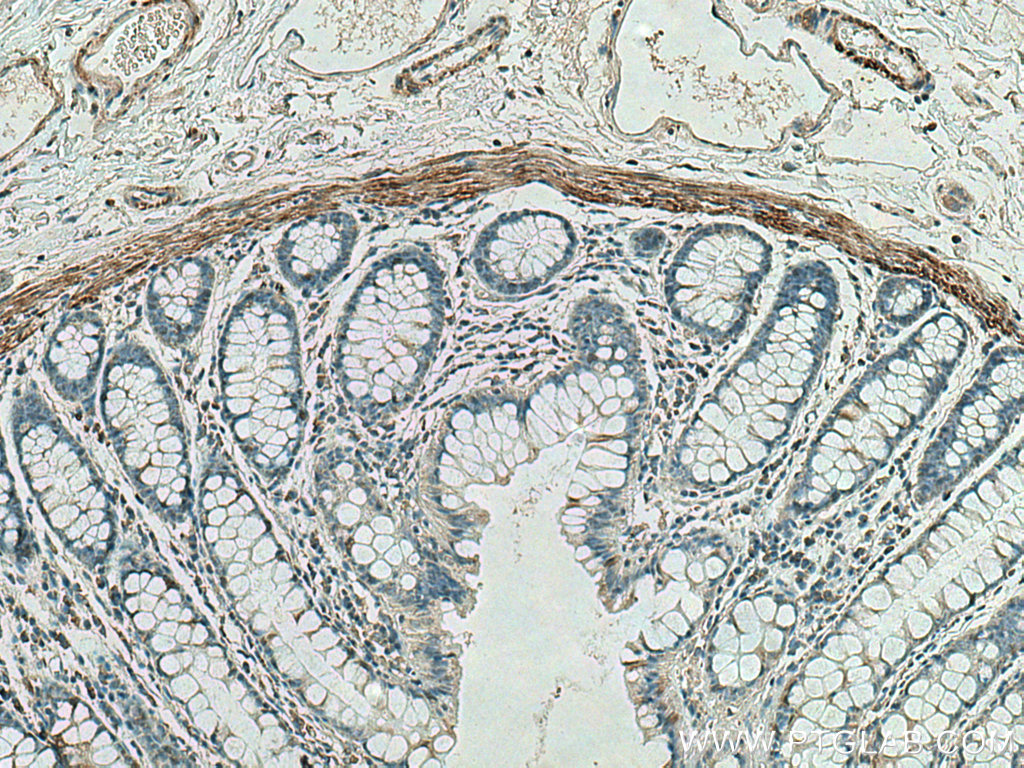

验证数据展示
经过测试的应用
| Positive WB detected in | pig heart tissue, mouse skeletal muscle tissue, mouse testis tissue, pig skeletal muscle, pig colon |
| Positive IHC detected in | human colon tissue, human placenta tissue, human rectal cancer tissue, mouse skeletal muscle tissue Note: suggested antigen retrieval with TE buffer pH 9.0; (*) Alternatively, antigen retrieval may be performed with citrate buffer pH 6.0 |
| Positive IF-P detected in | human colon tissue, human appendicitis tissue, mouse skeletal muscle tissue |
推荐稀释比
| 应用 | 推荐稀释比 |
|---|---|
| Western Blot (WB) | WB : 1:5000-1:50000 |
| Immunohistochemistry (IHC) | IHC : 1:1000-1:4000 |
| Immunofluorescence (IF)-P | IF-P : 1:200-1:800 |
| It is recommended that this reagent should be titrated in each testing system to obtain optimal results. | |
| Sample-dependent, Check data in validation data gallery. | |
发表文章中的应用
| WB | See 4 publications below |
| IF | See 8 publications below |
产品信息
67793-1-Ig targets Desmin in WB, IHC, IF-P, ELISA applications and shows reactivity with human, mouse, pig samples.
| 经测试应用 | WB, IHC, IF-P, ELISA Application Description |
| 文献引用应用 | WB, IF |
| 经测试反应性 | human, mouse, pig |
| 文献引用反应性 | human, mouse, rat |
| 免疫原 |
CatNo: Ag9675 Product name: Recombinant human Desmin protein Source: e coli.-derived, PET28a Tag: 6*His Domain: 121-470 aa of BC032116 Sequence: NYIEKVRFLEQQNAALAAEVNRLKGREPTRVAELYEEELRELRRQVEVLTNQRARVDVERDNLLDDLQRLKAKLQEEIQLKEEAENNLAAFRADVDAATLARIDLERRIESLNEEIAFLKKVHEEEIRELQAQLQEQQVQVEMDMSKPDLTAALRDIRAQYETIAAKNISEAEEWYKSKVSDLTQAANKNNDALRQAKQEMMEYRHQIQSYTCEIDALKGTNDSLMRQMRELEDRFASEASGYQDNIARLEEEIRHLKDEMARHLREYQDLLNVKMALDVEIATYRKLLEGEESRINLPIQTYSALNFRETSPEQRGSEVHTKKTVMIKTIETRDGEVVSEATQQQHEVL 种属同源性预测 |
| 宿主/亚型 | Mouse / IgG1 |
| 抗体类别 | Monoclonal |
| 产品类型 | Antibody |
| 全称 | desmin |
| 别名 | 2B1A11, DES |
| 计算分子量 | 470 aa, 54 kDa |
| 观测分子量 | 52 kDa |
| GenBank蛋白编号 | BC032116 |
| 基因名称 | Desmin |
| Gene ID (NCBI) | 1674 |
| RRID | AB_2918557 |
| 偶联类型 | Unconjugated |
| 形式 | Liquid |
| 纯化方式 | Protein G purification |
| UNIPROT ID | P17661 |
| 储存缓冲液 | PBS with 0.02% sodium azide and 50% glycerol, pH 7.3. |
| 储存条件 | Store at -20°C. Stable for one year after shipment. Aliquoting is unnecessary for -20oC storage. |
背景介绍
Desmin is the main intermediate filament protein in skeletal and cardiac muscle cells and is essential for both the structural integrity and the survival of muscle cells. As an abundant muscle-specific protein, desmin has been widely used as a marker of muscle derived tumors. Anti-desmin is also valuable in the differential diagnosis of tumors of uncertain origin.
实验方案
| Product Specific Protocols | |
|---|---|
| IF protocol for Desmin antibody 67793-1-Ig | Download protocol |
| IHC protocol for Desmin antibody 67793-1-Ig | Download protocol |
| WB protocol for Desmin antibody 67793-1-Ig | Download protocol |
| Standard Protocols | |
|---|---|
| Click here to view our Standard Protocols |
发表文章
| Species | Application | Title |
|---|---|---|
Gastroenterology Pancreatic acinar cells-derived sphingosine-1-phosphate contributes to fibrosis of chronic pancreatitis via inducing autophagy and activation of pancreatic stellate cells | ||
Mater Today Bio Engineered muscle from micro-channeled PEG scaffold with magnetic Fe3O4 fixation towards accelerating esophageal muscle repair | ||
J Oncol The Role of Purine Metabolism-Related Genes PPAT and IMPDH1 in the Carcinogenesis of Intrahepatic Cholangiocarcinoma Based on Metabonomic and Bioinformatic Analyses | ||
Exp Cell Res Bone marrow-derived mesenchymal stem cells transplantation attenuates renal fibrosis following acute kidney injury by repairing the peritubular capillaries | ||
DNA Cell Biol Single-Cell RNA Sequencing Technology Revealed the Pivotal Role of Fibroblast Heterogeneity in Angiotensin II-Induced Abdominal Aortic Aneurysms. | ||
Mol Cell Biochem Testosterone attenuates senile cavernous fibrosis by regulating TGFβR1 and galectin-1 signaling pathways through miR-22-3p |